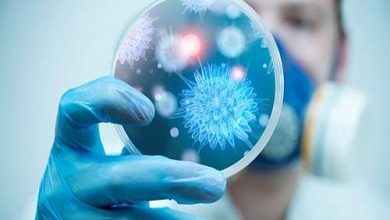

صحة و جمال
-

تسجيل 161 حالة مؤكدة و 508 حالات شفاء
أعلنت وزارة الصحة،الثلاثاء الجاري، عن تسجيل 161 حالة إصابة جديدة بفيروس كورونا المستجد (كوفيد-19)، و508 حالات شفاء، وحالتي وفاة خلال…
أكمل القراءة » -

111 حالة جديدة صباح يوم الثلاثاء و 469 متعافى
أعلنت وزارة الصحة عن تسجيل 111 إصابة مؤكدة جديدة بفيروس كورونا المستجد خلال الـ16 ساعة الماضية ، ليرتفع العدد الإجمالي…
أكمل القراءة » -

تسجيل 191 إصابة جديدة بفيروس كورونا في المغرب وارتفاع الحصيلة إلى 15936
أعلنت وزارة الصحة عن تسجيل 191 حالة إصابة جديدة بفيروس كورونا المستجد حتى السادسة من مساء يومه الإثنين ، ليرتفع…
أكمل القراءة » -

76 حالة حتى حدود العاشرة من يوم الاثنين، وارتفاع في عدد الحالات المتماثلة للشفاء
كشفت وزارة الصحة في نشرتها الوبائية صباح يوم الاثنين عن تسجيل 76 حالة إصابة مؤكدة جديدة بفيروس كورونا المستجد ،…
أكمل القراءة » -

السلطات تعيد فرض الحجر الصحي ببعض الأحياء بطنجة بعد ظهور بؤر لفيروس كورونا
ذكر بلاغ لوزارة الداخلية، أنه بالنظر لما تستدعيه الضرورة الصحية بعد أن تم تسجيل ظهور بؤر وبائية جديدة بمجموعة من…
أكمل القراءة » -
ارتفاع الحصيلة بالمغرب إلى 15745 بعد تسجيل 203 حالة بإصابة فيروس كورونا
أعلنت وزارة الصحة عن تسجيل 203 حالة إصابة جديدة بفيروس كورونا المستجد حتى السادسة من مساء يومه الأحد ، ليرتفع…
أكمل القراءة »

